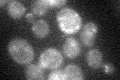
YBL010C
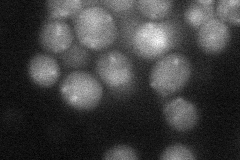
YBL010C
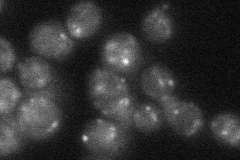
YBL010C
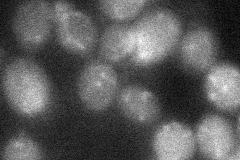
YBL010C
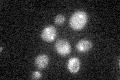
YBL010C

View description
Putative protein of unknown function; green fluorescent protein (GFP)-fusion protein colocalizes with clathrin-coated vesicles
Localization:
Intensity:
Fold change:
Significance:
-
C’ GFP library in SD
punctate20.95 -
N' NOP1pr-GFP in SD

punctate59.7839 -
N' TEF2pr-mCherry in SD
cytosol,punctate28.6393 -
N' NATIVEpr-GFP in SD
punctate28.5142 -
N' TEF2pr-VC and Cyto-VN in SD
below threshold28.2548 -
C’ GFP library in SD+DTT

punctate21.941.04No -
C’ GFP library in SD+H2O2

punctate22.261.06No -
C’ GFP library in Starvation Media
punctate25.471.21No -
C’ GFP library on the background of Pup2-DaMP

punctate -
C’ GFP library on the background of CCT mutant

punctate19.79920.944671No
